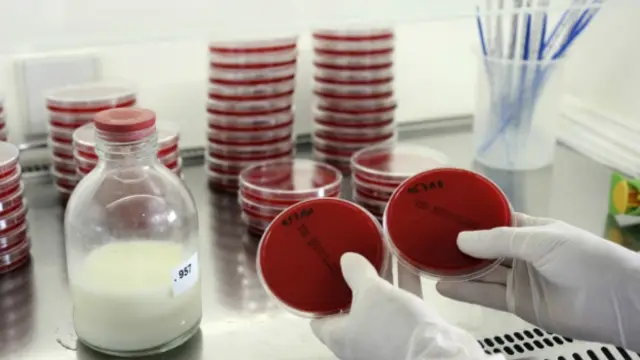
آزمایش شیر مادر از نظر آلودگی میکروبی در بانک شیر

دومین بانک شیر مادر در مشهد تاسیس میشود

منبع تصویر، BSIP
یکی از مقامهای بهداشتی استان خراسان رضوی در شمال شرقی ایران٬ از تاسیس بانک شیر مادر در مرکز این استان خبر داده است.
به گفته کاظم فرهمند٬ قائم مقام معاونت بهداشتی دانشگاه علوم پزشکی مشهد٬ بانک ذخیره شیر مادر با ۲۰۰ میلیون تومان بودجه در یکی از بیمارستانهای مشهد افتتاح میشود.
مشهد دومین شهری است که در آن بانک شیر مادر تاسیس میشود.
هدف از تاسیس این بانک تغذیه کودکان نارس است که نمیتوانند از شیر مادر خود استفاده کنند. قرار است مادرانی که این توانایی را دارند شیر اضافه خود را در اختیار این مراکز قرار دهند.

منبع تصویر،
شیرهای جمعآوری شده باید در دو مرحله پاستوریزه و همینطور آزمایش شود.
حدود دو هفته پیش اولین بانک شیر مادر ایران در شهر تبریز٬ مرکز استان آذربایجان شرقی افتتاح شد.
یونیسف٬ صندوق کودکان سازمان ملل متحد از مروجان تغذیه با شیر مادر و همینطور حامی ایجاد بانک شیر است که قرار است علاوه بر تبریز در سه نقطه دیگر ایران از جمله اصفهان و تهران تاسیس شود.
ویل پارکس٬ نماینده سازمان یونیسف در ایران درباره اهمیت ایجاد این بانک میگوید: "این کار میتواند باعث نجات کودکان نارس از مرگ شود و همینطور به رشد مغز آنان کمک کند."

- نخستین بانک شیر دنیا در سال ۱۹۰۹ در وین پایتخت اتریش افتتاح شد.
- در بریتانیا نخستین بانک شیر در سال ۱۹۳۹ آغاز به کار کرد.
- در آمریکا اولین بانک شیر در سال ۱۹۱۹ در بوستون گشایش یافت.
- بانک شیر مادر در بسیاری از کشورهای جهان وحود دارد.
- سازمان بهداشت جهانی برای نوزادی که مادرش شیر ندارد یا نمیتواند شیر بدهد، اولین و مهمترین جایگزین را شیر مادران دیگر میداند.
- سازمان ملل به شیر مادر لقب "واکسن اول" را داده است.

در بیمارستانها، مادران نوزادان نارس یا بیمار که جدا نگهداری میشوند٬ تشویق میشوند که شیر خود را بدوشند اما همه مادران نمیتوانند در روزهای اول بعد از زایمان شیر تولید کنند.
تمام نوزادان باید تا شش ماهگی فقط از شیر مادر یا شیر مخصوص نوزادان تغذیه کنند. توصیه میشود که تغذیه کمکی کودکان با مواد غذایی جامد از شش ماهگی آغاز شود و تا یکسالگی شیر مادر یا شیر مخصوص نوزاد منبع اصلی تغدیه کودک باشد.
منبع تصویر، SPL
بر اساس توصیههای پزشکی کودکان نباید تا قبل از یکسالگی شیر گاو یا شیر بز بخورند به این دلیل که دستگاه گوارشی آنان توانایی هضم این شیر را ندارد.
سازمان ملل بتازگی کمپینی را به نام 'برلفی' برای تشویق تغذیه با شیر مادر راه انداخته و از مادران خواسته عکس سلفی خود را در حال شیر دادن نوزادشان در مکانهای عمومی منتشر کنند.<link type="page"><caption> اینجا بیشتر بخوانید. </caption><url href="http://www.bbc.com/persian/science/2016/07/160729_me_un_brelfie" platform="highweb"/></link>











